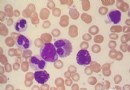

給新生兒穿衣有技巧
初為父母總是既欣喜又緊張,然而面對寶寶嬌小的軀體,很多父母給孩子穿衣時總是不知如何動手,怕傷了孩子。

其實,為全身柔軟的寶寶舒適地穿上衣服也是有技巧的,即理清穿衣順序,動作宜輕柔,順著寶寶肢體彎曲和活動的方向進行。
1、對於套頭衫而言,首先應先將上衣沿著領口折疊成圓圈狀,將兩個手指從中間伸進去把上衣領口撐開,然後從寶寶的頭部套過。為了避免套頭時寶寶因被遮住視線而恐懼,家長要一邊跟他說話一邊進行,以分散他的注意力。接著便是穿袖子,先把一只袖子沿袖口折疊成圓圈形,媽媽的手從中間穿過去後,握住寶寶的手腕從袖圈中輕輕拉過,順勢把衣袖套在寶寶的手臂上,然後以同樣的方式穿另一只衣袖。最後整理,一只手輕輕把寶寶托起,另一只手把上衣輕輕往拉下至平整。若是帶紐扣或是繩子的上衣,應先將衣服扣子或繩子解開平鋪於台面上,讓寶寶平躺在衣服上,脖子對准衣領的位置,然後用和上面同樣的方式把衣服套入寶寶的手臂,最後再扣好紐扣,系上繩子。穿連體服按同法進行。
2、穿褲子,應先把褲腿折疊成圓圈形,家長的手指從中穿過去後握住寶寶的足腕,將腳輕輕地拉過去。待穿好兩只褲腿之後抬起寶寶的腿,把褲子拉直。最後抱起寶寶把褲腰提上去包住上衣,並把衣服整理平整。
- 上一頁:怎樣應對新生兒經常打嗝?
- 下一頁:如何防止新生兒打嗝
- 新生兒護理
-
寶寶睡覺易醒怎麼辦?
寶寶睡覺易醒怎麼辦?
-
急,急,醫生,您好,寶寶誤食了不是很熟透
急,急,醫生,您好,寶寶誤食了不是很熟透 男21歲健康咨
-
寶寶20幾天大口溢奶正常嗎?
寶寶20幾天大口溢奶正常嗎
-
寶寶不吸奶瓶的問題如何解決
關鍵點讀:首先媽媽要做好心理准備,選好